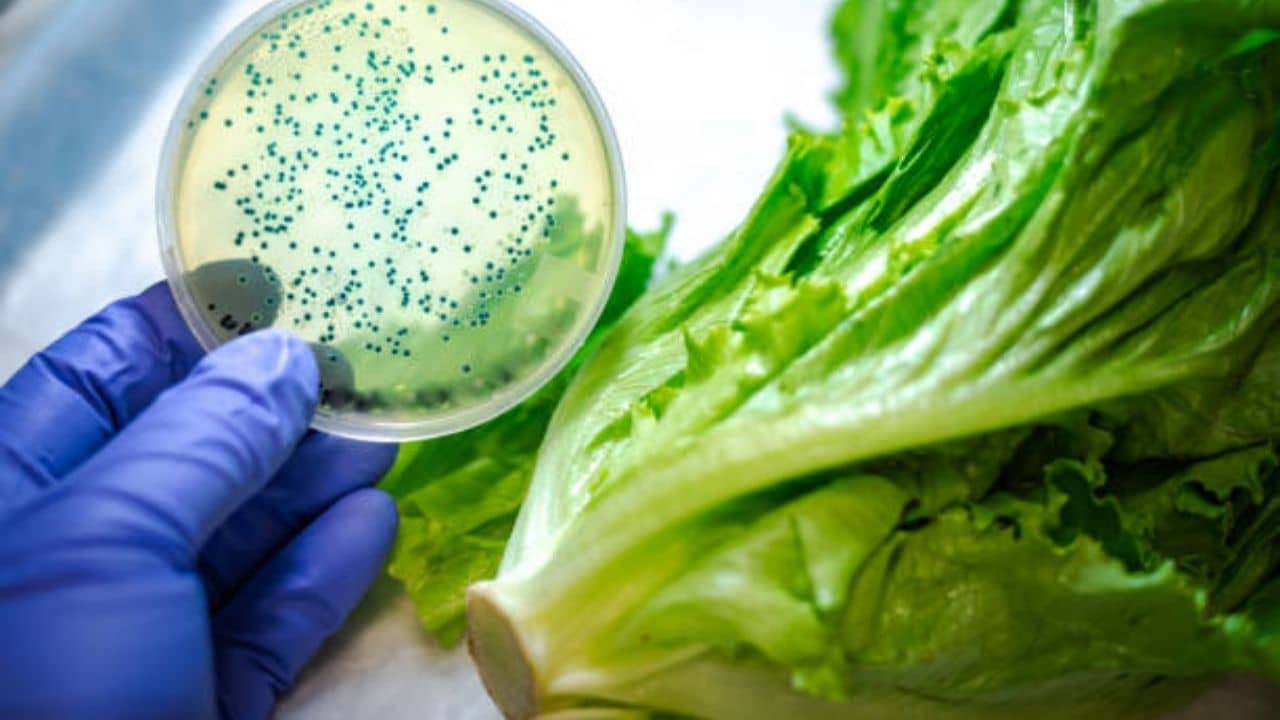

Food Science: বিজ্ঞানের সাহায্যে পুষ্টি সুরক্ষা এবং প্রোটিনের পর্যাপ্ততার অনেকটাই কাছাকাছি
চার্লস ডারউইন বলেছিলেন, "এটি বেঁচে থাকা প্রজাতির মধ্যে সবচেয়ে শক্তিশালী নয়, সবচেয়ে বুদ্ধিমানও নয়, তবে পরিবর্তনের জন্য আরও প্রতিক্রিয়াশীল।"
আরোপিত: ডঃ এইচ এন মিশ্র, খাদ্য প্রযুক্তির অধ্যাপক, কৃষি ও খাদ্য প্রকৌশল বিভাগের, ইন্ডিয়ান ইনস্টিটিউট অফ টেকনোলজি খড়গপুর, রাইট টু প্রোটিন ইনিসিয়েটিভের সমর্থক
১৯৬০ সালের বিখ্যাত সবুজ বিপ্লব পর থেকে অনেক দূর এগিয়েছে ভারত। আর তার পর থেকেই আমরা খাদ্য-অপ্রতুল দেশ থেকে একটি খাদ্য নিরাপদ দেশে রূপান্তরিত হতে পেরেছি। প্রায় ২ দশক ধরে খাবার-দাবারের আমদানির উপরে নির্ভরশীল থাকার পর বৈজ্ঞানিক পদ্ধতি এ দেশে খাদ্যের উৎপাদনশীলতা বাড়াতে সাহায্য করেছে। কিন্তু দুঃখজনক ভাবে, প্রায় ১৯০ মিলিয়ন মানুষ ভারতে বসবাস করেন, যাঁরা অপুষ্টিতে ভুগছেন এবং সেই পরিসংখ্যান আমাদের জনসংখ্যার প্রায় ১৪ শতাংশ। যদিও বন্টন বৈষম্য এবং নিম্ন কৃষি উৎপাদনশীলতা এই দুঃখজনক পরিস্থিতির জন্য অনেকাংশে দায়ী হলেও প্রোটিন, ভিটামিন এবং খনিজগুলির অভাবের পরিপ্রেক্ষিতে কেউ অপুষ্টি উপেক্ষা করতে পারেন না যা ভারতের বিশাল জনসংখ্যাকে ব্যাপক ভাবে প্রভাবিত করে।
ইন্ডিয়ান কাউন্সিল অফ মেডিক্যাল রিসার্চের একটি রিপোর্ট অনুসারে, একজন প্রাপ্তবয়স্ক মানুষের দৈনিক প্রতি কেজি ওজনের ০.৮১-১ গ্রাম প্রোটিন খাওয়া উচিত। কিন্তু পরিসংখ্যান বলছে, গড় ভারতীয় প্রাপ্তবয়স্কদের এই হিসেবে যথেষ্ট ঘাটতি রয়েছে এবং ০.৬ গ্রামের কাছাকাছি প্রোটিন খাওয়া হচ্ছে এ দেশে। প্রাপ্তবয়স্কদের মধ্যে প্রোটিনের ঘাটতি হলে পেশি হ্রাস, দুর্বল রোগ প্রতিরোধ ক্ষমতা এবং কোনও ক্ষতের নিরাময় হতে বেশ কিছুটা সময় লেগে যায়। ভারতীয় শিশুরাও ভয়ানক প্রোটিন এনার্জি অপুষ্টিতে ভুগছে, যেখানে ২০১৯-২১ সালে ৩৮.৪% অবচেতন, ২১% নষ্ট এবং ৩৫.৬% কম ওজনের ছিল।
চাল এবং গমের মতো প্রধান শস্য খাওয়ার উপর নির্ভরশীল থাকার ফলেই খাদ্যের বৈচিত্র্য এবং অন্যান্য পুষ্টি গ্রহণের বিষয়টি বাধাপ্রাপ্ত হয়েছে, যা শরীরের কার্যকারিতা ভারসাম্য বজায় রাখার জন্য অত্যন্ত গুরুত্বপূর্ণ। ন্যাশনাল নিউট্রিশন মনিটরিং বোর্ডের সমীক্ষাগুলি থেকে দেখা গিয়েছে, ভারতের খাদ্যগুলি তাদের প্রায় ৬০% প্রোটিন বিভিন্ন শস্য থেকে আহরণ করে যার তুলনামূলকভাবে কম হজমযোগ্যতা এবং গুণমান রয়েছে। ভাল পুষ্টির বিষয়ে অতিরিক্ত চাপও দেওয়া যাবে না, বিশেষ করে করোনাভাইরাস অতিমারির পরে যখন মানুষের স্বাস্থ্য এবং সুস্থতায় রীতিমতো বিপর্যয় দেখা দিয়েছে। আর সেই সব দিক বিচার করেই বলা যায় যে, ভারতের খাদ্য পরিবেশকে নতুন আকার দিতে এবং খাদ্যের উৎসকে বৈচিত্র্যময় করার জন্য আবার বিজ্ঞানের দিকে ফিরে যাওয়ার সময় এসেছে।
চার্লস ডারউইন যেমনটা বলেছিলেন, “এটি বেঁচে থাকা প্রজাতির মধ্যে সবচেয়ে শক্তিশালী নয়, সবচেয়ে বুদ্ধিমানও নয়, তবে পরিবর্তনের জন্য আরও প্রতিক্রিয়াশীল।”
খাদ্য প্রক্রিয়াকরণ প্রযুক্তি এবং প্রকৌশলের উন্নয়নগুলি সুস্বাদু, পুষ্টিকর, এবং নান্দনিক ভাবে প্যাকেজ আকারে সারা বছর ধরে বিভিন্ন ধরণের খাবার উপলব্ধ করতে গুরুত্বপূর্ণ ভূমিকা পালন করে। জেনেটিক পরিবর্তন, মাটির উর্বরতা উন্নত করার প্রযুক্তিগত ভাবে উন্নত পদ্ধতি এবং স্মার্ট প্রোটিনের বর্ধিত সংগ্রহ পুষ্টিকর খাবারের প্রাপ্যতা বাড়াতেও সাহায্য করতে পারে।
যদিও ৭০ শতাংশের বেশি ভারতীয় আমিষভোজী, মাংস খাওয়া তার অযোগ্য প্রকৃতির কারণে দুষ্প্রাপ্যও বটে। দুধ এবং ডাল প্রোটিনের একটি যৌক্তিক প্রাথমিক উৎস হয়ে ওঠে। যাইহোক, ডালের চাহিদা ভারতে তাদের উৎপাদনের চেয়ে অনেক বেশি এবং সেগুলির সবই উচ্চমানের প্রোটিন নয়। প্রোটিন-সুরক্ষিত খাবার এবং প্রোটিন সম্পূরকগুলির পাশাপাশি প্রোটিনের অন্যান্য উচ্চ-মানের উদ্ভিদ-ভিত্তিক বিকল্পগুলির মাধ্যমে এই ব্যবধানটি পূরণে সহায়ক হতে পারে কেবল মাত্র খাদ্য-বিজ্ঞান। যদিও ভারতে প্রচুর শস্য বৈচিত্র্য রয়েছে, কৃষি উৎপাদনের মাত্র ১০ শতাংশ প্রক্রিয়াজাত করা হয়। অব্যবহৃত এবং কম অন্বেষণ করা প্রোটিন এবং মাইক্রোনিউট্রিয়েন্ট-সমৃদ্ধ খাদ্য শস্যের উপযুক্ত প্রক্রিয়াকরণ এবং উদ্ভাবনী পণ্য বিকাশের বিষয় হওয়া উচিত যাতে সেগুলি কনজ়িউমারদের কাছে সহজলভ্য হয়।
খাদ্য-বিজ্ঞানের আর এক ফসল, ফুড ফোর্টিফিকেশন যা প্রয়োজনীয় মাইক্রো এবং ম্যাক্রোনিউট্রিয়েন্ট সরবরাহ করার জন্য সাধারণ ভাবে ব্যবহৃত স্টেপল ব্যবহার করার অসাধারণ সম্ভাবনা রয়েছে। এটি খাদ্য প্রক্রিয়া শিল্প থেকে প্রাপ্ত উপ-পণ্যগুলিকে উচ্চ-মূল্যের এবং পুষ্টিকর পণ্যগুলিতে রূপান্তর করতে পারে। উপজাত হিসেবে প্রাপ্ত ডালকে মিশ্রিত করে অপরিহার্য অ্যামিনো অ্যাসিড সুষম ডাল অ্যানালগ তৈরি করা যেতে পারে। উদ্ভাবনী পণ্য যেমন, উচ্চ মানের প্রোটিন-সহ উদ্ভিজ্জ মাংস বিভিন্ন প্রোটিন-সমৃদ্ধ উদ্ভিদ উৎস যেমন চিনাবাদাম, সয়াবিন, মাশরুম, মাইসেলিয়াম ইত্যাদির সমন্বয়ে তৈরি করা যেতে পারে। এই উদ্ভাবনী প্রযুক্তি এবং পণ্যগুলির কম কার্বনের ব্যবসহার ক্রমবর্ধমান জনসংখ্যার জন্য প্রোটিনের গুণমান এবং প্রাপ্যতা উন্নত করে। ফসল কাটার পরের কার্যক্রম এবং কৃষিজাত পণ্য ও প্রাণীজ পণ্যের প্রক্রিয়াকরণে অভিনব ও উদ্ভাবনী পদ্ধতি ব্যবহার করে পুষ্টি উপাদান নষ্ট হওয়া রোধ করা যায়। প্রয়োজনীয় লক্ষ্যবস্তু পুষ্টির সংযোজন এবং খাদ্য শিল্প থেকে উপজাত হিসাবে হারিয়ে যাওয়া প্রোটিন, ভিটামিন এবং খনিজগুলির ব্যবহার করে নতুন পণ্যের বিকাশের মাধ্যমে পুষ্টি নিরাপত্তার পথ প্রশস্ত করে।
আর এই সব দিক মিলিয়েই অস্বীকার করার উপায় নেই যে, খাদ্য বিজ্ঞান এবং প্রযুক্তির ব্যাপক গ্রহণযোগ্যতা বৈজ্ঞানিক বিশ্লেষণ এবং অবহিত মতামত দ্বারা সমর্থিত উন্নত স্বাস্থ্য এবং সুস্থতার জন্য নতুন খাদ্য অভ্যাস গ্রহণকে অনুপ্রাণিত করবে। আর তার ফলেই খাদ্য ভবিষ্যতবাদের পথে নেতৃত্ব দেবে।